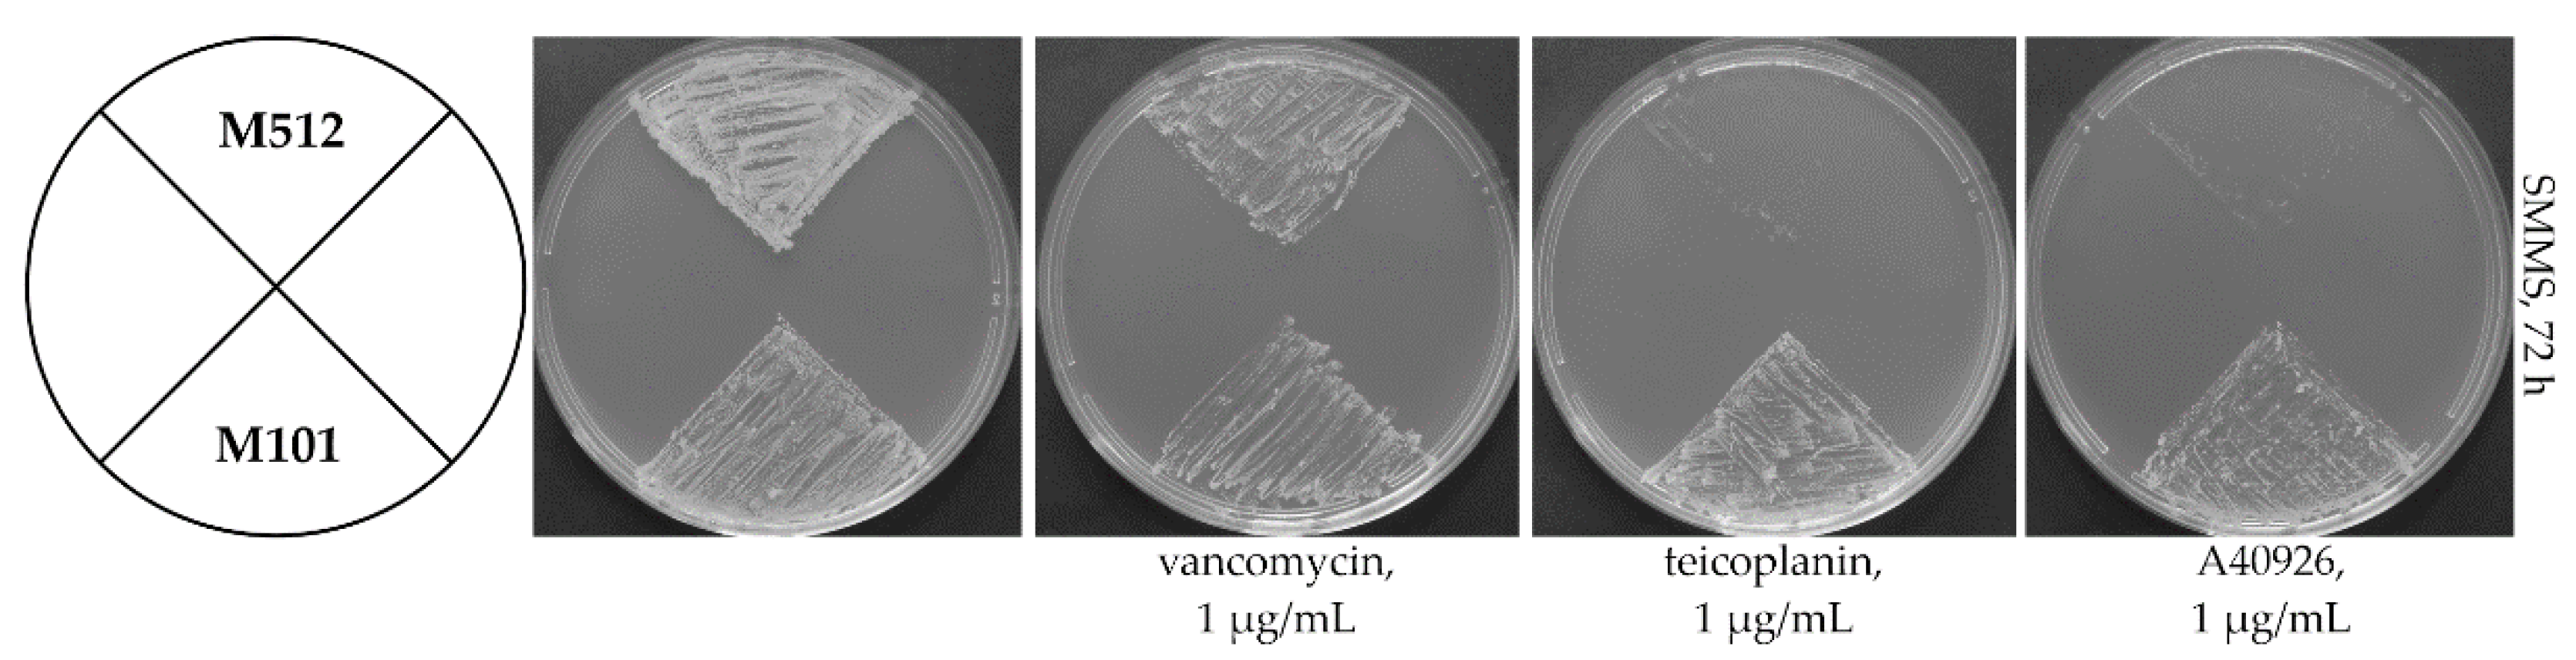
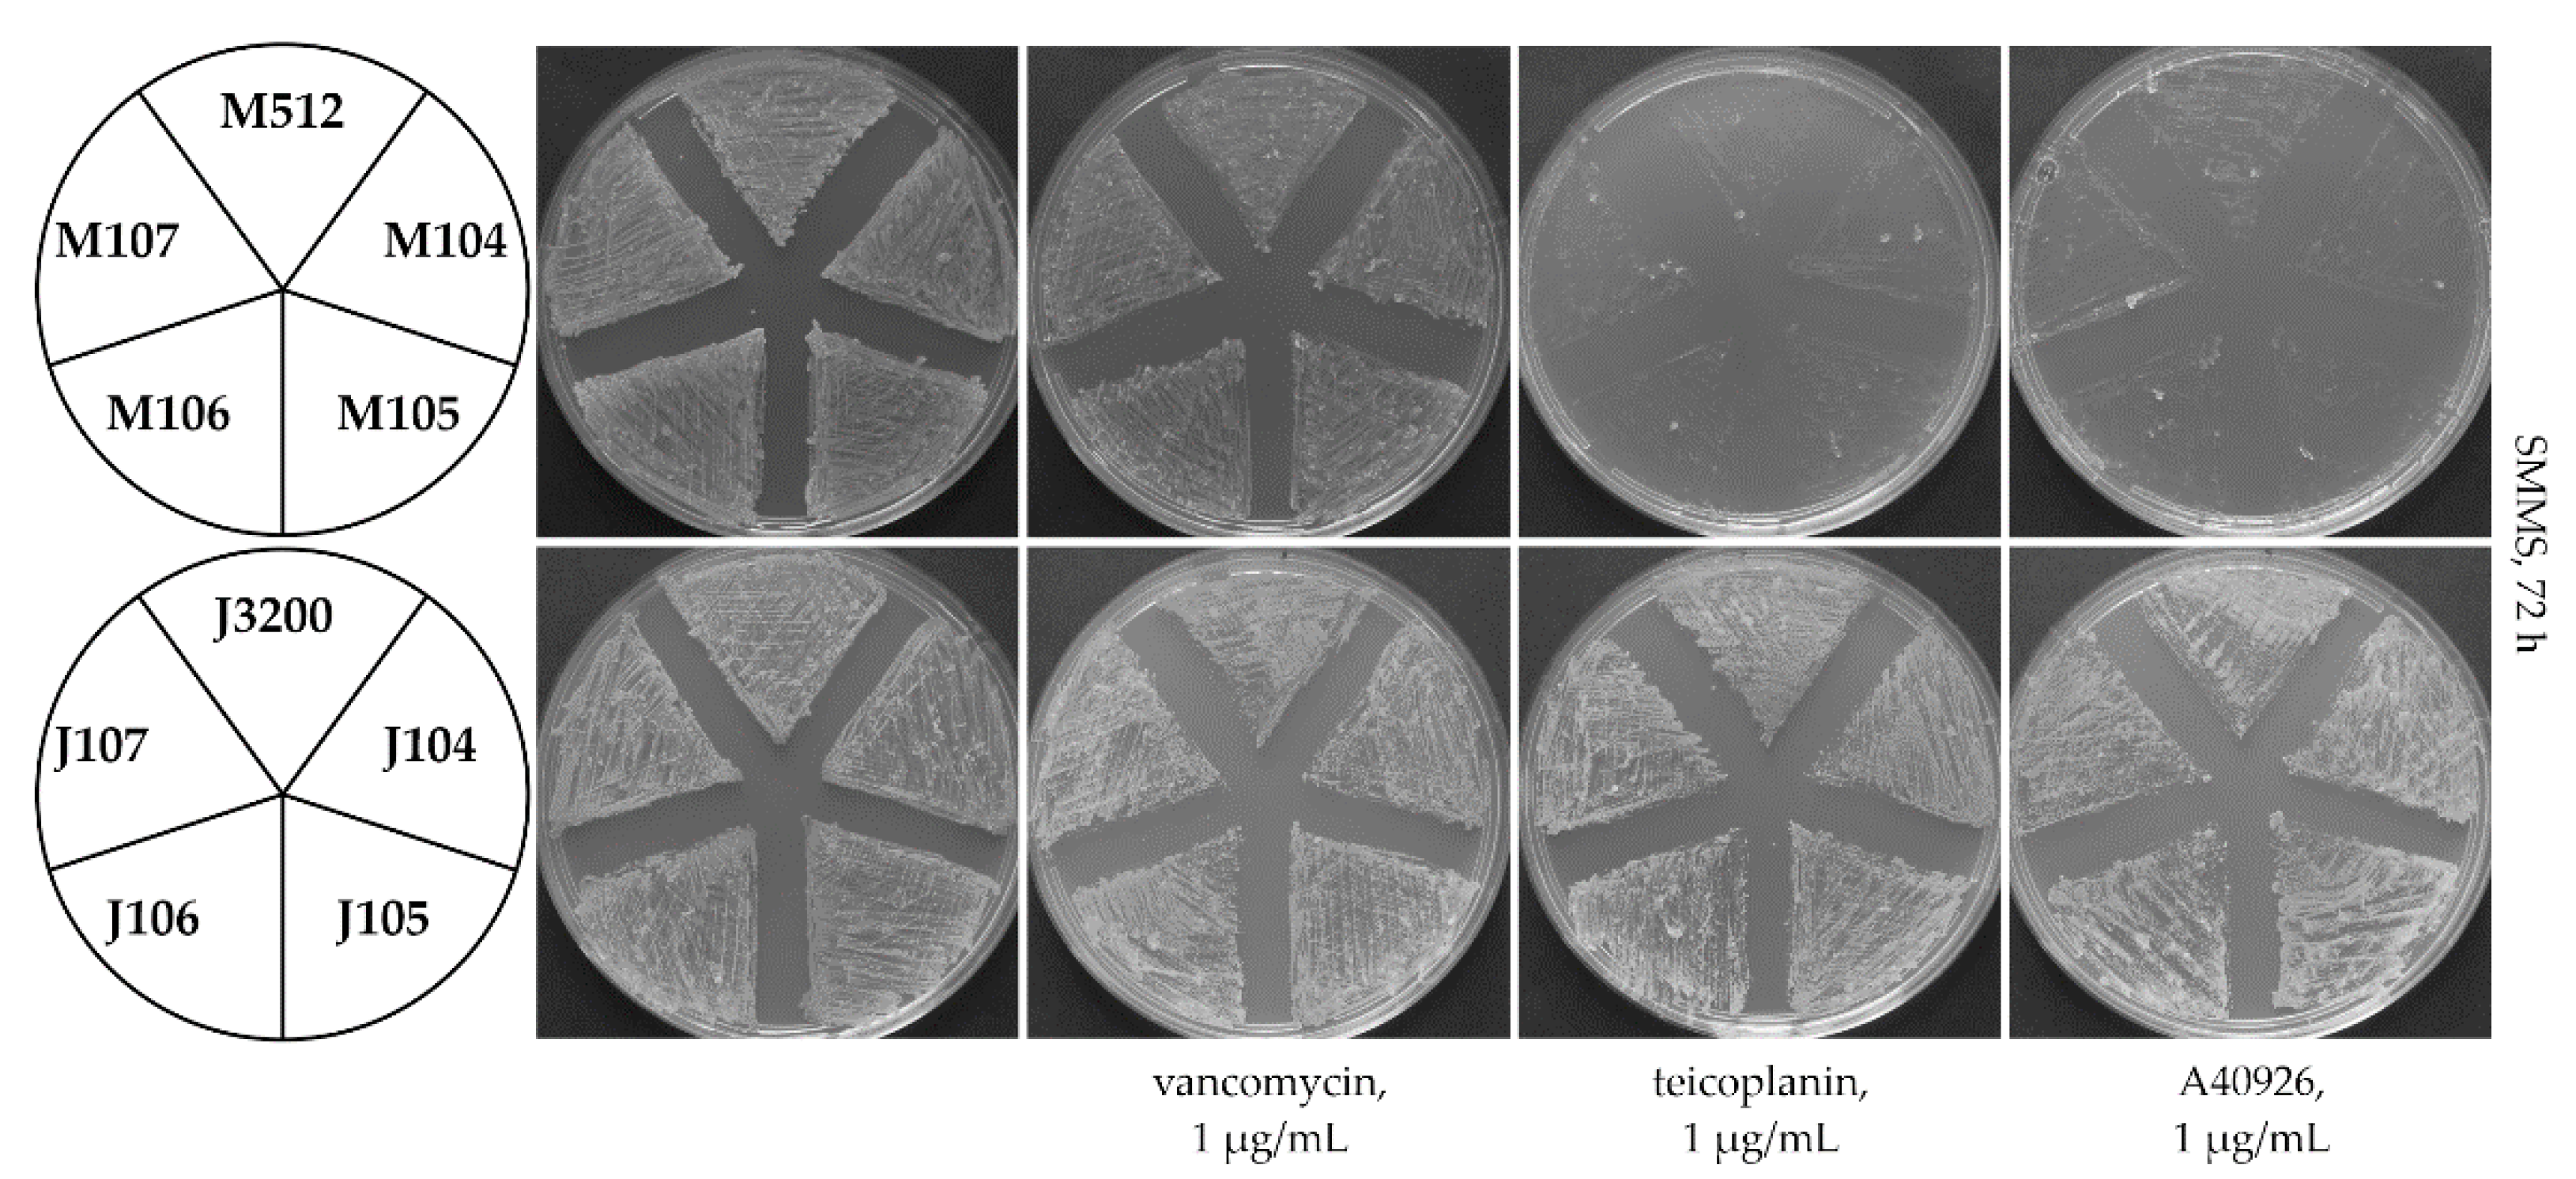
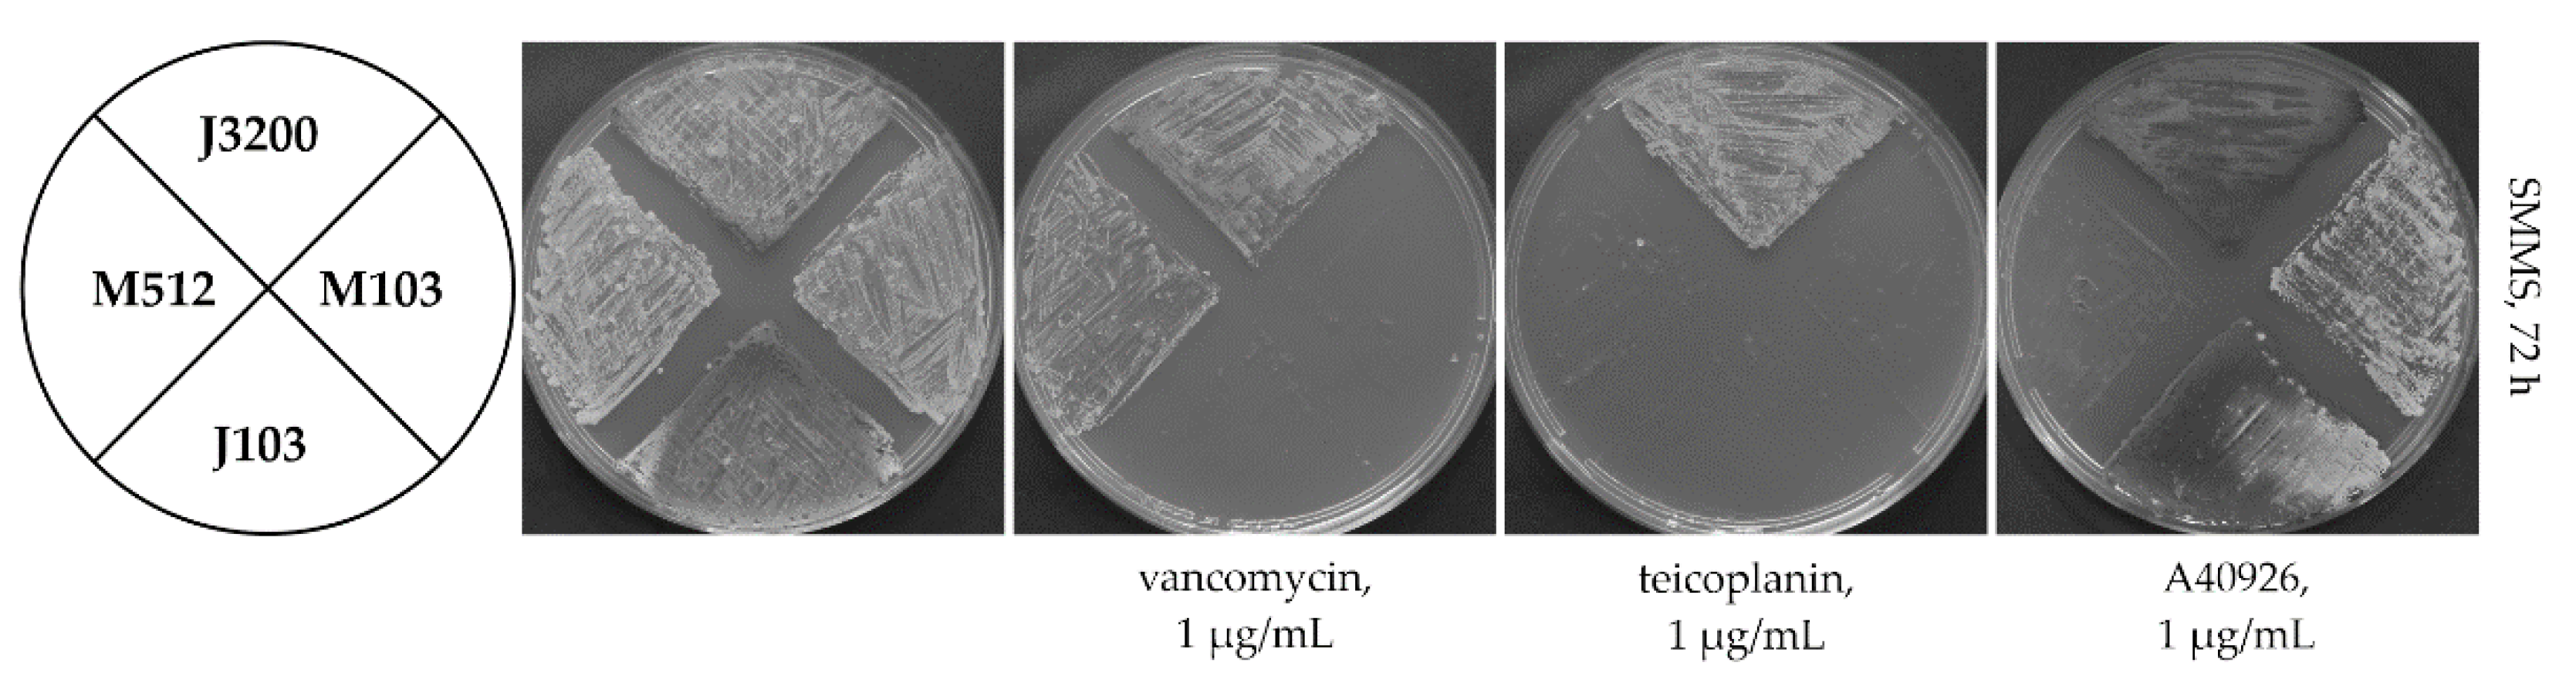

Heterologous Expression Reveals Ancient Properties of Tei3—A VanS Ortholog from the Teicoplanin Producer Actinoplanes teichomyceticus
Abstract
1. Introduction
2. Results
2.1. Heterologous Expression of Tei3 SHK Leads to Teicoplanin and A40926 Resistance in S. coelicolor M512
2.2. Tei3 Acts as a Non-Inducible Phosphorylase
2.3. Loss of Extracytoplasmic Sensory Loop and Transmembrane Helices Renders Tei3 and VanSSc Nonfunctional
2.4. Tei3 Sensor Domain Is Sensitive to A40926 but Not to Teicoplanin and Vancomycin
2.5. Establishing a Link between the Evolution of Glycosylation Pattern of Teicoplanin and Properties of Tei3 SD
3. Discussion


4. Materials and Methods
4.1. Plasmids, Bacterial Strains, and Cultivation Conditions
4.2. Generation of Recombinant Plasmids for Gene Expression and Promoter-Probe Vectors
4.3. Conjugal Transfer of Recombinant Plasmids to S. coelicolor Strains
4.4. Qualitative and Quantitative Glucuronidase Assays
4.5. Tools for In Silico Analysis
Supplementary Materials
Author Contributions
Funding
Institutional Review Board Statement
Informed Consent Statement
Data Availability Statement
Acknowledgments
Conflicts of Interest
References
- Nicolaou, K.C.; Boddy, C.N.C.; Bräse, S.; Winssinger, N. Chemistry, biology, and medicine of the glycopeptide antibiotics. Angew. Chem. Int. Ed. 1999, 38, 2096–2152. [Google Scholar] [CrossRef]
- Parenti, F.; Cavalleri, B. Proposal to name the vancomycin-ristocetin like glycopeptides as dalbaheptides. J. Antibiot. 1989, 42, 1882–1883. [Google Scholar] [CrossRef] [PubMed]
- Marcone, G.L.; Binda, E.; Berini, F.; Marinelli, F. Old and new glycopeptide antibiotics: From product to gene and back in the post-genomic era. Biotechnol. Adv. 2018, 36, 534–554. [Google Scholar] [CrossRef] [PubMed]
- Binda, E.; Marinelli, F.; Marcone, G.L. Old and new glycopeptide antibiotics: Action and resistance. Antibiotics 2014, 3, 572–594. [Google Scholar] [CrossRef] [PubMed]
- Thaker, M.N.; Wright, G.D. Opportunities for synthetic biology in antibiotics: Expanding glycopeptide chemical diversity. ACS Synth. Biol. 2015, 4, 195–206. [Google Scholar] [CrossRef] [PubMed]
- Butler, M.S.; Hansford, K.A.; Blaskovich, M.A.T.; Halai, R.; Cooper, M.A. Glycopeptide antibiotics: Back to the future. J. Antibiot. 2014, 67, 631–644. [Google Scholar] [CrossRef]
- Van Bambeke, F. Lipoglycopeptide antibacterial agents in gram-positive infections: A comparative review. Drugs 2015, 75, 2073–2095. [Google Scholar] [CrossRef]
- McCormick, M.H.; McGuire, J.M.; Pittenger, G.E.; Pittenger, R.C.; Stark, W.M. Vancomycin, a new antibiotic. I. Chemical and biologic properties. Antibiot. Annu. 1955, 3, 606–611. [Google Scholar]
- Malabarba, A.; Strazzolini, P.; Depaoli, A.; Landi, M.; Berti, M.; Cavalleri, B. Teicoplanin, antibiotics from Actinoplanes teichomyceticus nov. sp. VI. Chemical degradation: Physico-chemical and biological properties of acid hydrolysis products. J. Antibiot. 1984, 37, 988–999. [Google Scholar] [CrossRef]
- Leadbetter, M.R.; Adams, S.M.; Bazzini, B.; Fatheree, P.R.; Karr, D.E.; Krause, K.M.; Lam, B.M.T.; Linsell, M.S.; Nodwell, M.B.; Pace, J.L.; et al. Hydrophobic vancomycin derivatives with improved ADME properties: Discovery of telavancin (TD-6424). J. Antibiot. 2004, 57, 326–336. [Google Scholar] [CrossRef]
- Cooper, R.D.; Snyder, N.J.; Zweifel, M.J.; Staszak, M.A.; Wilkie, S.C.; Nicas, T.I.; Mullen, D.L.; Butler, T.F.; Rodriguez, M.J.; Huff, B.E.; et al. Reductive alkylation of glycopeptide antibiotics: Synthesis and antibacterial activity. J. Antibiot. 1996, 49, 575–581. [Google Scholar] [CrossRef] [PubMed][Green Version]
- Steiert, M.; Schmitz, F.-J. Dalbavancin (Biosearch Italia/Versicor). Curr. Opin. Investig. Drugs 2002, 3, 229–233. [Google Scholar] [PubMed]
- Melegh, S.; Nyul, A.; Kovács, K.; Kovács, T.; Ghidán, Á.; Dombrádi, Z.; Szabó, J.; Berta, B.; Lesinszki, V.; Pászti, J.; et al. Dissemination of VanA-type Enterococcus faecium isolates in Hungary. Microb. Drug Resist. 2018, 24, 1376–1390. [Google Scholar] [CrossRef] [PubMed]
- Gold, H.S. Vancomycin-resistant enterococci: Mechanisms and clinical observations. Clin. Infect. Dis. 2001, 33, 210–219. [Google Scholar] [CrossRef]
- Boneca, I.G.; Chiosis, G. Vancomycin resistance: Occurrence, mechanisms and strategies to combat it. Expert Opin. Ther. Targets 2003, 7, 311–328. [Google Scholar] [CrossRef]
- Pootoolal, J.; Neu, J.; Wright, G.D. Glycopeptide antibiotic resistance. Annu. Rev. Pharmacol. Toxicol. 2002, 42, 381–408. [Google Scholar] [CrossRef]
- Marshall, C.G.; Broadhead, G.; Leskiw, B.K.; Wright, G.D. d-Ala-d-Ala ligases from glycopeptide antibiotic-producing organisms are highly homologous to the enterococcal vancomycin-resistance ligases VanA and VanB. Proc. Natl. Acad. Sci. USA 1997, 94, 6480–6483. [Google Scholar] [CrossRef]
- Andreo-Vidal, A.; Binda, E.; Fedorenko, V.; Marinelli, F.; Yushchuk, O. Genomic insights into the distribution and phylogeny of glycopeptide resistance determinants within the Actinobacteria phylum. Antibiotics 2021, 10, 1533. [Google Scholar] [CrossRef]
- Yushchuk, O.; Binda, E.; Fedorenko, V.; Marinelli, F. Occurrence of vanHAX and related genes beyond the Actinobacteria phylum. Genes 2022, 13, 1960. [Google Scholar] [CrossRef]
- Williams, D.H. The glycopeptide story—How to kill the deadly “superbugs”. Nat. Prod. Rep. 1996, 13, 469–477. [Google Scholar] [CrossRef]
- Arthur, M.; Molinas, C.; Bugg, T.D.H.; Wright, G.D.; Walsh, C.T.; Courvalin, P. Evidence for in vivo incorporation of d-lactate into peptidoglycan precursors of vancomycin-resistant enterococci. Antimicrob. Agents Chemother. 1992, 36, 867–869. [Google Scholar] [CrossRef] [PubMed]
- Marcone, G.L.; Beltrametti, F.; Binda, E.; Carrano, L.; Foulston, L.; Hesketh, A.; Bibb, M.; Marinelli, F. Novel mechanism of glycopeptide resistance in the A40926 producer Nonomuraea sp. ATCC 39727. Antimicrob. Agents Chemother. 2010, 54, 2465–2472. [Google Scholar] [CrossRef]
- Marcone, G.L.; Binda, E.; Carrano, L.; Bibb, M.; Marinelli, F. Relationship between glycopeptide production and resistance in the actinomycete Nonomuraea sp. ATCC 39727. Antimicrob. Agents Chemother. 2014, 58, 5191–5201. [Google Scholar] [CrossRef]
- Binda, E.; Marcone, G.L.; Pollegioni, L.; Marinelli, F. Characterization of VanYn, a novel d,d-peptidase/d,d- carboxypeptidase involved in glycopeptide antibiotic resistance in Nonomuraea sp. ATCC 39727. FEBS J. 2012, 279, 3203–3213. [Google Scholar] [CrossRef] [PubMed]
- Reynolds, P.E.; Depardieu, F.; Dutka-Malen, S.; Arthur, M.; Courvalin, P. Glycopeptide resistance mediated by enterococcal transposon Tn1546 requires production of VanX for hydrolysis of d-alanyl-d-alanine. Mol. Microbiol. 1994, 13, 1065–1070. [Google Scholar] [CrossRef] [PubMed]
- Wu, Z.; Wright, G.D.; Walsh, C.T. Overexpression, purification, and characterization of VanX, a d-,d-dipeptidase which is essential for vancomycin resistance in Enterococcus faecium BM4147. Biochemistry 1995, 34, 2455–2463. [Google Scholar] [CrossRef] [PubMed]
- Bugg, T.D.; Wright, G.D.; Dutka-Malen, S.; Arthur, M.; Courvalin, P.; Walsh, C.T. Molecular basis for vancomycin resistance in Enterococcus faecium BM4147: Biosynthesis of a depsipeptide peptidoglycan precursor by vancomycin resistance proteins VanH and VanA. Biochemistry 1991, 30, 10408–10415. [Google Scholar] [CrossRef]
- Arthur, M.; Quintiliani, R., Jr. Regulation of VanA- and VanB-type glycopeptide resistance in enterococci. Antimicrob. Agents Chemother. 2001, 45, 375–381. [Google Scholar] [CrossRef]
- Koteva, K.; Hong, H.J.; Wang, X.D.; Nazi, I.; Hughes, D.; Naldrett, M.J.; Buttner, M.J.; Wright, G.D. A vancomycin photoprobe identifies the histidine kinase VanSsc as a vancomycin receptor. Nat. Chem. Biol. 2010, 6, 327–329. [Google Scholar] [CrossRef]
- Kwun, M.J.; Novotna, G.; Hesketh, A.R.; Hill, L.; Hong, H.J. In vivo studies suggest that induction of VanS-dependent vancomycin resistance requires binding of the drug to d-Ala-d-Ala termini in the peptidoglycan cell wall. Antimicrob. Agents Chemother. 2013, 57, 4470–4480. [Google Scholar] [CrossRef]
- Hutchings, M.I.; Hong, H.J.; Buttner, M.J. The vancomycin resistance VanRS two-component signal transduction system of Streptomyces coelicolor. Mol. Microbiol. 2006, 59, 923–935. [Google Scholar] [CrossRef] [PubMed]
- Hong, H.J.; Paget, M.S.B.; Buttner, M.J. A signal transduction system in Streptomyces coelicolor that activates expression of a putative cell wall glycan operon in response to vancomycin and other cell wall-specific antibiotics. Mol. Microbiol. 2002, 44, 1199–1211. [Google Scholar] [CrossRef] [PubMed]
- Novotna, G.B.; Kwun, M.J.; Hong, H.J. In vivo characterization of the activation and interaction of the VanR-VanS two-component regulatory system controlling glycopeptide antibiotic resistance in two related Streptomyces species. Antimicrob. Agents Chemother. 2016, 60, 1627–1637. [Google Scholar] [CrossRef] [PubMed]
- Yushchuk, O.; Binda, E.; Marinelli, F. Glycopeptide antibiotic resistance genes: Distribution and function in the producer actinomycetes. Front. Microbiol. 2020, 11, 1173. [Google Scholar] [CrossRef]
- Beltrametti, F.; Consolandi, A.; Carrano, L.; Bagatin, F.; Rossi, R.; Leoni, L.; Zennaro, E.; Selva, E.; Marinelli, F. Resistance to glycopeptide antibiotics in the teicoplanin producer is mediated by van gene homologue expression directing the synthesis of a modified cell wall peptidoglycan. Antimicrob. Agents Chemother. 2007, 51, 1135–1141. [Google Scholar] [CrossRef]
- Yushchuk, O.; Horbal, L.; Ostash, B.; Marinelli, F.; Wohlleben, W.; Stegmann, E.; Fedorenko, V. Regulation of teicoplanin biosynthesis: Refining the roles of tei cluster-situated regulatory genes. Appl. Microbiol. Biotechnol. 2019, 103, 4089–4102. [Google Scholar] [CrossRef]
- Yushchuk, O.; Homoniuk, V.; Ostash, B.; Marinelli, F.; Fedorenko, V. Genetic insights into the mechanism of teicoplanin self-resistance in Actinoplanes teichomyceticus. J. Antibiot. 2020, 73, 255–259. [Google Scholar] [CrossRef]
- Floriano, B.; Bibb, M. afsR is a pleiotropic but conditionally required regulatory gene for antibiotic production in Streptomyces coelicolor A3(2). Mol. Microbiol. 1996, 21, 385–396. [Google Scholar] [CrossRef]
- Hong, H.J.; Hutchings, M.I.; Neu, J.M.; Wright, G.D.; Paget, M.S.B.; Buttner, M.J. Characterization of an inducible vancomycin resistance system in Streptomyces coelicolor reveals a novel gene (vanK) required for drug resistance. Mol. Microbiol. 2004, 52, 1107–1121. [Google Scholar] [CrossRef]
- Kilian, R.; Frasch, H.J.; Kulik, A.; Wohlleben, W.; Stegmann, E. The VanRS homologous two-component system VnlRSAb of the glycopeptide producer Amycolatopsis balhimycina activates transcription of the vanHAXSc genes in Streptomyces coelicolor, but not in A. balhimycina. Microb. Drug Resist. 2016, 22, 499–509. [Google Scholar] [CrossRef]
- Sievers, F.; Higgins, D.G. Clustal omega. Curr. Protoc. Bioinform. 2014, 48, 1–33. [Google Scholar] [CrossRef] [PubMed]
- Marchler-Bauer, A.; Bryant, S.H. CD-Search: Protein domain annotations on the fly. Nucleic Acids Res. 2004, 32, 327–331. [Google Scholar] [CrossRef] [PubMed]
- Binda, E.; Cappelletti, P.; Marinelli, F.; Marcone, G.L. Specificity of induction of glycopeptide antibiotic resistance in the producing actinomycetes. Antibiotics 2018, 7, 36. [Google Scholar] [CrossRef]
- Myronovskyi, M.; Welle, E.; Fedorenko, V.; Luzhetskyy, A. β-Glucuronidase as a sensitive and versatile reporter in Actinomycetes. Appl. Environ. Microbiol. 2011, 77, 5370–5383. [Google Scholar] [CrossRef] [PubMed]
- Kieser, T.; Bibb, M.J.; Buttner, M.J.; Chater, K.F.; Hopwood, D.A. Practical Streptomyces Genetics; John Innes Foundation: Norwich, UK, 2000. [Google Scholar]
- Gregory, M.A.; Till, R.; Smith, M.C.M. Integration site for Streptomyces phage φBT1 and development of site-specific integrating vectors. J. Bacteriol. 2003, 185, 5320–5323. [Google Scholar] [CrossRef] [PubMed]
- Yushchuk, O.; Vior, N.M.; Andreo-Vidal, A.; Berini, F.; Rückert, C.; Busche, T.; Binda, E.; Kalinowski, J.; Truman, A.W.; Marinelli, F. Genomic-led discovery of a novel glycopeptide antibiotic by Nonomuraea coxensis DSM 45129. ACS Chem. Biol. 2021, 16, 915–928. [Google Scholar] [CrossRef]
- Yushchuk, O.; Ostash, B.; Truman, A.W.; Marinelli, F.; Fedorenko, V. Teicoplanin biosynthesis: Unraveling the interplay of structural, regulatory, and resistance genes. Appl. Microbiol. Biotechnol. 2020, 104, 3279–3291. [Google Scholar] [CrossRef]
- Donadio, S.; Sosio, M.; Stegmann, E.; Weber, T.; Wohlleben, W. Comparative analysis and insights into the evolution of gene clusters for glycopeptide antibiotic biosynthesis. Mol. Genet. Genom. 2005, 274, 40–50. [Google Scholar] [CrossRef]
- Yushchuk, O.; Zhukrovska, K.; Berini, F.; Fedorenko, V.; Marinelli, F. Genetics behind the glycosylation patterns in the biosynthesis of dalbaheptides. Front. Chem. 2022, 10, 858708. [Google Scholar] [CrossRef]
- Truman, A.W.; Kwun, M.J.; Cheng, J.; Yang, S.H.; Suh, J.W.; Hong, H.J. Antibiotic resistance mechanisms inform discovery: Identification and characterization of a novel Amycolatopsis strain producing ristocetin. Antimicrob. Agents Chemother. 2014, 58, 5687–5695. [Google Scholar] [CrossRef]
- Yushchuk, O.; Ostash, B.; Pham, T.H.; Luzhetskyy, A.; Fedorenko, V.; Truman, A.W.; Horbal, L. Characterization of the post-assembly line tailoring processes in teicoplanin biosynthesis. ACS Chem. Biol. 2016, 11, 2254–2264. [Google Scholar] [CrossRef] [PubMed]
- Xu, M.; Wang, W.; Waglechner, N.; Culp, E.J.; Guitor, A.K.; Wright, G.D. GPAHex—A synthetic biology platform for type IV–V glycopeptide antibiotic production and discovery. Nat. Commun. 2020, 11, 5232. [Google Scholar] [CrossRef] [PubMed]
- Kruse, T.; Levisson, M.; de Vos, W.M.; Smidt, H. vanI: A novel d-Ala-d-Lac vancomycin resistance gene cluster found in Desulfitobacterium hafniense. Microb. Biotechnol. 2014, 7, 456–466. [Google Scholar] [CrossRef]
- Foucault, M.-L.; Courvalin, P.; Grillot-Courvalin, C. Fitness cost of VanA-type vancomycin resistance in methicillin-resistant Staphylococcus aureus. Antimicrob. Agents Chemother. 2009, 53, 2354–2359. [Google Scholar] [CrossRef] [PubMed]
- Foucault, M.-L.; Depardieu, F.; Courvalin, P.; Grillot-Courvalin, C. Inducible expression eliminates the fitness cost of vancomycin resistance in enterococci. Proc. Natl. Acad. Sci. USA 2010, 107, 16964–16969. [Google Scholar] [CrossRef]
- Heide, L. The aminocoumarins: Biosynthesis and biology. Nat. Prod. Rep. 2009, 26, 1241–1250. [Google Scholar] [CrossRef]
- Tamura, K.; Stecher, G.; Kumar, S. MEGA11: Molecular Evolutionary Genetics Analysis Version 11. Mol. Biol. Evol. 2021, 38, 3022–3027. [Google Scholar] [CrossRef]
- Jones, D.T.; Taylor, W.R.; Thornton, J.M. The rapid generation of mutation data matrices from protein sequences. Bioinformatics 1992, 8, 275–282. [Google Scholar] [CrossRef]
- Schäberle, T.F.; Vollmer, W.; Frasch, H.J.; Hüttel, S.; Kulik, A.; Röttgen, M.; Von Thaler, A.K.; Wohlleben, W.; Stegmann, E. Self-resistance and cell wall composition in the glycopeptide producer Amycolatopsis balhimycina. Antimicrob. Agents Chemother. 2011, 55, 4283–4289. [Google Scholar] [CrossRef]
- Frasch, H.J.; Kalan, L.; Kilian, R.; Martin, T.; Wright, G.D.; Stegmann, E. Alternative pathway to a glycopeptide-resistant cell wall in the balhimycin producer Amycolatopsis balhimycina. ACS Infect. Dis. 2016, 1, 243–252. [Google Scholar] [CrossRef]
- Koshla, O.; Lopatniuk, M.; Rokytskyy, I.; Yushchuk, O.; Dacyuk, Y.; Fedorenko, V.; Luzhetskyy, A.; Ostash, B. Properties of Streptomyces albus J1074 mutant deficient in tRNALeuUAA gene bldA. Arch. Microbiol. 2017, 199, 1175–1183. [Google Scholar] [CrossRef] [PubMed]
- Horbal, L.; Kobylyanskyy, A.; Yushchuk, O.; Zaburannyi, N.; Luzhetskyy, A.; Ostash, B.; Marinelli, F.; Fedorenko, V. Evaluation of heterologous promoters for genetic analysis of Actinoplanes teichomyceticus—Producer of teicoplanin, drug of last defense. J. Biotechnol. 2013, 168, 367–372. [Google Scholar] [CrossRef] [PubMed]
- Kearse, M.; Moir, R.; Wilson, A.; Stones-Havas, S.; Cheung, M.; Sturrock, S.; Buxton, S.; Cooper, A.; Markowitz, S.; Duran, C.; et al. Geneious Basic: An integrated and extendable desktop software platform for the organization and analysis of sequence data. Bioinformatics 2012, 28, 1647–1649. [Google Scholar] [CrossRef] [PubMed]

| Name | Characteristic | Reference |
|---|---|---|
| Plasmids: | ||
| pSET152A | φC31-based integrative plasmid, pSET152 derivative carrying aac(3)IVp from pIJ773, Amr | [63] |
| pKC1132 | suicide vector, Amr | [45] |
| pRT801 | φBT1-based integrative plasmid, Amr | [46] |
| pGUS | φC31-based integrative plasmid, pSET152 derivative containing promoterless GusA, Amr, Spr | [44] |
| pGP101 | pSET152A derivative carrying tei3 | this work |
| pGP111 | pRT801 derivative carrying tei3 | this work |
| pGP102 | pSET152A derivative carrying SCO3589 (vanSSc) | this work |
| pKC1132-102 | pKC1132 derivative carrying SCO3589 (vanSSc) | this work |
| pKC1132-103 | pKC1132 derivative carrying hybrid SHK gene with tei3-SD and vanSSc-ATPaseD | this work |
| pGP103 | pSET152A derivative carrying hybrid SHK gene with tei3-SD and vanSSc-ATPaseD | this work |
| pGP104 | pSET152A derivative carrying tei3′ | this work |
| pGP105 | pSET152A derivative carrying SCO3589′ | this work |
| pGP106 | pSET152A derivative carrying tei3″ | this work |
| pGP107 | pSET152A derivative carrying SCO3589″ | this work |
| pGJp | pGUS derivative carrying vanJp | this work |
| pHJp | pGUS derivative carrying vanHp | this work |
| Strains: | ||
| A. teichomyceticus ATCC 31121 | wild type, teicoplanin producer | ATCC |
| S. coelicolor M512 | A3(2) derivative, ΔredD ΔactII-ORF4 SCP1− SCP2− | [38] |
| S. coelicolor J3200 | A3(2) derivative, ΔSCO3589 (vanSSc) | [31] |
| S. coelicolor M101 | M512 derivative carrying pGP101 | this work |
| S. coelicolor M111 | M512 derivative carrying pGP111 | this work |
| S. coelicolor pGJp+ | M512 derivative carrying pGJp | this work |
| S. coelicolor pGHp+ | M512 derivative carrying pGHp | this work |
| S. coelicolor M1J | M512 derivative carrying pGJp and pGP111 | this work |
| S. coelicolor M103 | M512 derivative carrying pGP103 | this work |
| S. coelicolor M104 | M512 derivative carrying pGP104 | this work |
| S. coelicolor M105 | M512 derivative carrying pGP105 | this work |
| S. coelicolor M106 | M512 derivative carrying pGP106 | this work |
| S. coelicolor M107 | M512 derivative carrying pGP107 | this work |
| S. coelicolor J103 | J3200 derivative carrying pGP103 | this work |
| S. coelicolor J104 | J3200 derivative carrying pGP104 | this work |
| S. coelicolor J105 | J3200 derivative carrying pGP105 | this work |
| S. coelicolor J106 | J3200 derivative carrying pGP106 | this work |
| S. coelicolor J107 | J3200 derivative carrying pGP107 | this work |
| Name | Sequence (5′-3′) * | Purpose |
|---|---|---|
| tei3_sdomain_PaeI | CGAGCATGCGACCGGCCAG | Reverse primer for cloning the tei3 region coding for the sensor domain |
| tei3_F | TTTGATATCGGAGGGAGACCGTGGACCGAGCCC | Cloning of the tei3 and its truncated versions |
| tei3’_F | TTTGATATCGGAGGGAGACCGTGTTCGCCCCGGCGACGG | -//- |
| tei3”_F | TTTGATATCGGAGGAGACCGTGGGTCGGATGCTCGCTCCTCT | -//- |
| tei3_R | TTTGAATTCGCGGTGGGCGGTTCAGTTT | -//- |
| SCO3589_F | TTTGATATCGGAGGGCGACGGTGGATAGGCGCC | Cloning of the SCO3589 (vanSSc) and its truncated versions |
| SCO3589’_F | TTTGATATCGGAGGGAGACCGTGCTTCGCAGTTTCGCCC | -//- |
| SCO3589’’_F | TTTGATATCGGAGGGCGACGGTGGGACGCATGCTCGCCCCCCT | -//- |
| SCO3589_R | TTTGAATTCTGGCGCTCACCTGCCGGTG | -//- |
| vanHp_KpnI_F | TTTGGTACCTACGTCCACACCGCCGAGC | Cloning of vanHSc promoter region into pGUS |
| vanHp_SpeI_R | TTTACTAGTGCCGTCCCGTATGCGCTTT | -//- |
| vanJp_KpnI_F | TTTGGTACCACACTCAGCAGCTCCAACG | Cloning of vanJSc promoter region into pGUS |
| vanJp_SpeI_R | TTTACTAGTCTGGCGCCGGTGCGGCCGA | -//- |
| aac(3)IV_F | ATCGACTGATGTCATCAGCG | Diagnostic primers for the amplification of aac(3)IV gene |
| aac(3)IV_R | CGAGCTGAAGAAAGACAAT | -//- |
| gusA_ver_F | GGCGGCTACACGCCCTTCGA | Diagnostic primers for the amplification of 1000 bp internal region of gusA |
| gusA_ver_R | TGATGGGCCGGGTGGGGTC | -//- |
Publisher’s Note: MDPI stays neutral with regard to jurisdictional claims in published maps and institutional affiliations. |
© 2022 by the authors. Licensee MDPI, Basel, Switzerland. This article is an open access article distributed under the terms and conditions of the Creative Commons Attribution (CC BY) license (https://creativecommons.org/licenses/by/4.0/).
Share and Cite
Yushchuk, O.; Zhukrovska, K.; Ostash, B.; Fedorenko, V.; Marinelli, F. Heterologous Expression Reveals Ancient Properties of Tei3—A VanS Ortholog from the Teicoplanin Producer Actinoplanes teichomyceticus. Int. J. Mol. Sci. 2022, 23, 15713. https://doi.org/10.3390/ijms232415713
Yushchuk O, Zhukrovska K, Ostash B, Fedorenko V, Marinelli F. Heterologous Expression Reveals Ancient Properties of Tei3—A VanS Ortholog from the Teicoplanin Producer Actinoplanes teichomyceticus. International Journal of Molecular Sciences. 2022; 23(24):15713. https://doi.org/10.3390/ijms232415713
Chicago/Turabian StyleYushchuk, Oleksandr, Kseniia Zhukrovska, Bohdan Ostash, Victor Fedorenko, and Flavia Marinelli. 2022. "Heterologous Expression Reveals Ancient Properties of Tei3—A VanS Ortholog from the Teicoplanin Producer Actinoplanes teichomyceticus" International Journal of Molecular Sciences 23, no. 24: 15713. https://doi.org/10.3390/ijms232415713
APA StyleYushchuk, O., Zhukrovska, K., Ostash, B., Fedorenko, V., & Marinelli, F. (2022). Heterologous Expression Reveals Ancient Properties of Tei3—A VanS Ortholog from the Teicoplanin Producer Actinoplanes teichomyceticus. International Journal of Molecular Sciences, 23(24), 15713. https://doi.org/10.3390/ijms232415713

